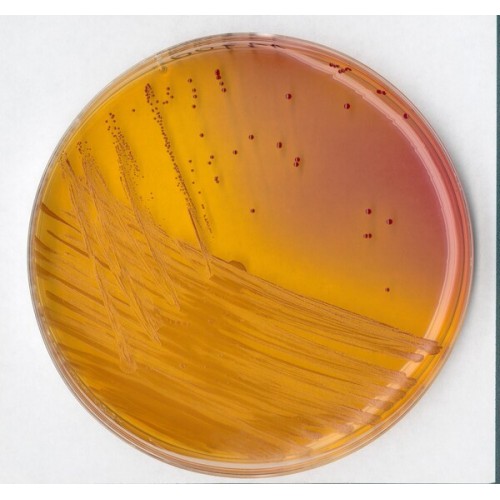

AGAR KF PARA STREPTOCOCCUS 500GR MERCK
Modelo: 1107070500
-
R$1.032,42
ou até 3x de R$344,14 sem juros
Economize 5% no PIX: R$980,80
ou 3.5% no boleto: R$996,29
Consulte aqui o valor do frete e prazo de entrega
Descrição
KF STREPTOCOCCUS AGAR BASE MERCK
RENDIMENTO 71,5g/l
EMBALAGEM 500GR
Mode of Action
Maltose and lactose are metabolized by most enterococci with the production of acid and thus promote the growth of these bacteria; undesired microorganisms are largely supressed by sodium azide. Acid formation is detected by bromocresol purple which changes its colour to yellow. Enterococci reduce TTC to give a red formazan and thus appear as red colonies.
Typical Composition (g/litre)
Proteose peptone 10.0; yeast extract 10.0; sodium chloride 5.0; sodium glycerophosphate 10.0; maltose 20.0; lactose 1.0; sodium azide 0.4; bromocresol purple 0.015; agar-agar 15.0.
Also to be added: 2,3,5-triphenyltetrazolium chloride 0.1.
Preparation
Suspend 71.5 g in 1 litre of demin. water. Bring to the boil with frequent agitation. Boil for 5 minutes (or utoclave 10 min at 121°C, if total selectivity is required).
RENDIMENTO 71,5g/l
EMBALAGEM 500GR
Mode of Action
Maltose and lactose are metabolized by most enterococci with the production of acid and thus promote the growth of these bacteria; undesired microorganisms are largely supressed by sodium azide. Acid formation is detected by bromocresol purple which changes its colour to yellow. Enterococci reduce TTC to give a red formazan and thus appear as red colonies.
Typical Composition (g/litre)
Proteose peptone 10.0; yeast extract 10.0; sodium chloride 5.0; sodium glycerophosphate 10.0; maltose 20.0; lactose 1.0; sodium azide 0.4; bromocresol purple 0.015; agar-agar 15.0.
Also to be added: 2,3,5-triphenyltetrazolium chloride 0.1.
Preparation
Suspend 71.5 g in 1 litre of demin. water. Bring to the boil with frequent agitation. Boil for 5 minutes (or utoclave 10 min at 121°C, if total selectivity is required).